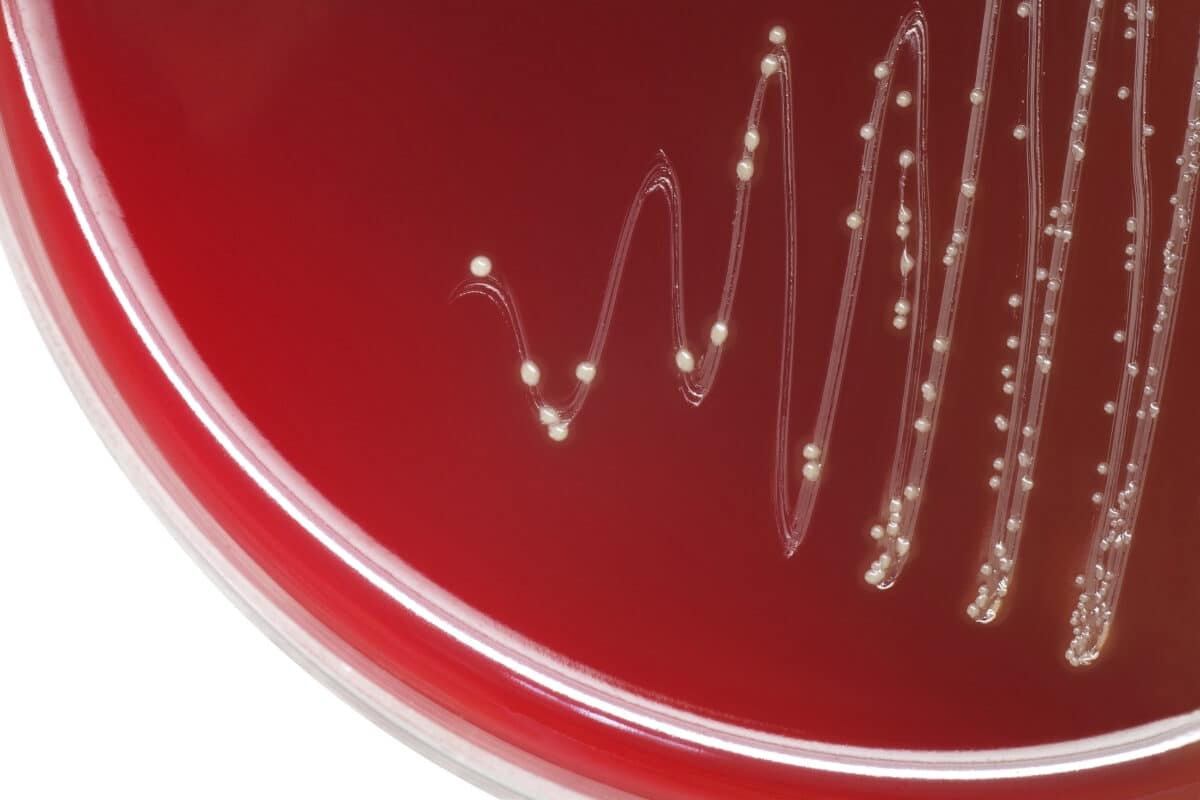
Streptococcus bacterial colonies

Streptococcus bacterial colonies with alpha hemolytic on blood agar plate. (© Chansom Pantip - stock.adobe.com)
In A Nutshell
- Researchers found mouth bacteria (viridans streptococci) inside arterial plaques of sudden death victims and surgical patients.
- These bacteria formed biofilms — hidden colonies that evade immune defenses and resist antibiotics.
- When activated, the bacteria may trigger inflammation that weakens plaques, making ruptures and heart attacks more likely.
- Findings suggest prevention may need to go beyond cholesterol control to include strategies that target bacterial biofilms.
TAMPERE, Finland — Heart attacks are typically linked to high cholesterol or stress problems, but new research shows they could also be linked to bacteria hiding in your arteries for years. Scientists have discovered that common mouth bacteria form stealth colonies inside heart arteries, evading the immune system until they suddenly activate and help set off the chain of events that can lead to heart attacks.
The research, which examined arterial tissue from 217 people, including sudden death victims, reveals that the common mouth bacteria, viridans streptococci, can establish hidden biofilm communities within arterial plaques. These bacterial colonies remain undetected by immune cells for extended periods before dispersing and triggering the inflammation that leads to arterial ruptures.
The study, published in the Journal of the American Heart Association, found strong associations between bacterial presence and both severe artery disease and death from heart problems.
How Mouth Bacteria Reach Heart Arteries
Viridans streptococci usually live peacefully in the mouth, where they are among the first bacteria to attach to teeth and form dental plaque. They can slip into the bloodstream during everyday activities like brushing teeth, dental cleanings, or even chewing food, especially if gums are inflamed.
Most people quickly clear these bacteria from the bloodstream, but the new study shows they may find permanent refuge in atherosclerotic plaques. Once there, they form biofilms. These are sophisticated bacterial communities protected by shields that antibiotics can’t penetrate and immune cells can’t detect.
Scientists found these bacterial colonies in 42.1% of coronary plaques from sudden death victims and 42.9% of surgical samples from patients undergoing arterial procedures. DNA analysis confirmed that viridans streptococci were the most common bacteria detected, though other oral bacteria also showed up.
Researchers note that bacteria may attach as biofilms onto the uneven surfaces of plaques after episodes of bacteria entering the bloodstream (transient bacteremia). Whether this process always has clinical significance is still under investigation.

From Hidden Colonies to Sudden Activation
“Viridans streptococci colonized the core of the atheroma as a biofilm unrecognized by macrophages of the innate immune system,” the researchers reported. Macrophages are immune cells responsible for identifying and destroying invaders, but they seemed blind to these hidden bacterial communities.
These biofilms don’t always remain dormant. The study suggests they “may be activated by some poorly known factors,” producing more aggressive bacteria that then disperse from the biofilm. Once awakened, these bacteria become visible to the immune system, which floods the area and sparks inflammation.
Unlike the hidden biofilms, these activated bacteria were found infiltrating the ruptured areas of arterial plaques in people who died from heart attacks. Laboratory studies showed that the immune system’s response produced enzymes that break down the plaque’s structure, making rupture and heart attack more likely.
Why Previous Antibiotic Trials Failed
The discovery may explain a long-standing puzzle. For years, researchers suspected infections played a role in heart disease, leading to large clinical trials testing whether antibiotics could reduce heart attacks. Most of those trials failed, leaving doubts about the infection theory.
Biofilm-forming bacteria offer a clear explanation. Biofilms resist antibiotics because bacteria inside them exist in a protected, dormant state. Treatments that work against active infections are powerless against entrenched colonies.
“Currently, it is known that chronic inflammation is often due to a bacterial biofilm that can evade the innate immune system and is resistant to antibiotics, which possibly may explain the trial failures,” the researchers wrote.
A New Look at Heart Attack Prevention
Rather than seeing heart attacks only as the result of cholesterol buildup and lifestyle factors, this study suggests they might also involve long-dormant bacterial infections inside arterial walls. People with seemingly healthy cholesterol levels who still suffer sudden cardiac death may be victims of this bacterial activation rather than traditional risk factors alone.
The same research group has found viridans streptococci in blood clots from stroke patients and ruptured brain aneurysms, suggesting these organisms may contribute to dangerous events throughout the body. Earlier studies by the team also found that sudden cardiac death victims often had worse dental health than average.
Poor oral hygiene creates more chances for bacteria to enter the bloodstream and potentially settle in arteries. However, once biofilms are established, they may persist for years as hidden triggers within arterial walls.
Preventing heart attacks may one day go beyond cholesterol and blood pressure management to include strategies that detect and disrupt bacterial biofilms. Such treatments could open new possibilities for protecting against sudden cardiac death.
Disclaimer: This article is for informational purposes only and is not a substitute for professional medical advice, diagnosis, or treatment. Always seek the advice of your physician or another qualified health provider with any questions you may have regarding a medical condition. Do not disregard professional medical advice or delay seeking it because of something you have read here.
Paper Summary
Methodology
Researchers analyzed arterial tissue from two groups: 121 people who died suddenly outside hospitals (autopsy samples) and 96 patients undergoing vascular surgery. They used bacterial DNA analysis, immunohistochemistry to detect bacterial proteins, and genome-wide expression analysis to study immune responses.
Results
Viridans streptococcal DNA was found in 42.1% of coronary plaques from sudden death victims and 42.9% of surgical samples. These bacteria formed biofilms that evaded immune detection but could disperse and trigger inflammation. Bacterial presence correlated strongly with severe artery disease and death from heart problems.
Limitations
The study population was mostly male (about 74% of autopsy cases and 72% of surgical patients were men), which may limit how well the results apply to women. Some surgical samples were too small for complete analysis, and researchers couldn’t always confirm whether aggressive bacteria came from biofilms or elsewhere. Calcified samples sometimes prevented DNA testing.
Funding and Disclosures
The research was supported by the European Union 7th Framework Program, Finnish Foundation for Cardiovascular Research, Jane and Aatos Erkko Foundation, and others. One author (Reijo Laaksonen) is affiliated with Zora Biosciences. Other authors reported no conflicts of interest.
Publication Information
“Viridans Streptococcal Biofilm Evades Immune Detection and Contributes to Inflammation and Rupture of Atherosclerotic Plaques” was published in the Journal of the American Heart Association, 2025;14:e041521. DOI: 10.1161/JAHA.125.041521.







